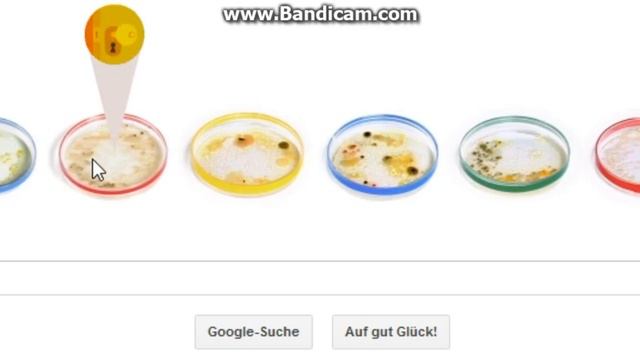
Google Doodle * Julius Richard Petri * 31.05.2013 * Bakteriologe

Похожее видео
×
GuitarHero 3 - Tom Morello Battle PC Medium

Видео: GuitarHero 3 - Tom Morello Battle PC Medium
2024-09-22 в 16:27:06
2024-09-22 в 03:36:55
2026-04-18 в 18:46:18
2024-09-22 в 12:47:50
2024-09-22 в 12:58:07
2024-09-22 в 17:24:20
2024-09-22 в 14:32:05
2026-04-18 в 18:45:17
2024-09-22 в 03:45:26